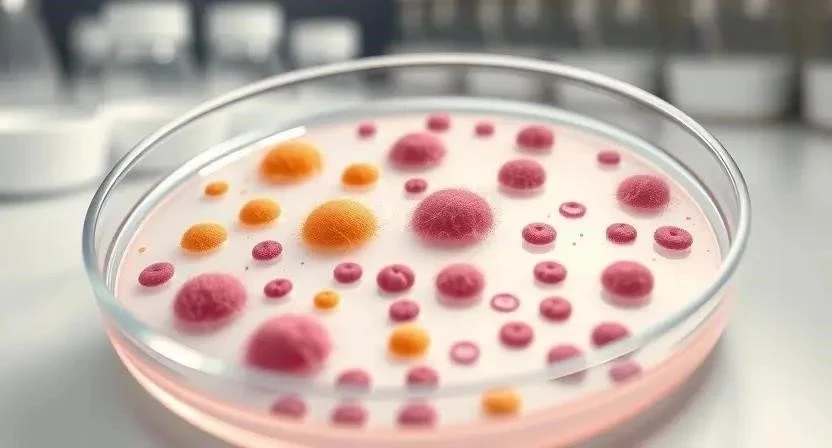

Замечали ли вы, как быстро дети приносят домой новые микробы? Повышенная температура, насморк, кашель – это может быть как обычная простуда, так и признак бактериальной инфекции. По статистике, бактериальные инфекции составляют значительную часть всех детских заболеваний. Важно вовремя распознать симптомы и начать лечение, чтобы избежать осложнений. В этой статье мы подробно разберем, как отличить бактериальную инфекцию у ребенка от вирусной, какие анализы необходимо сдать и какое лечение будет наиболее эффективным.
Что такое бактериальные инфекции
Бактериальные инфекции вызываются микроскопическими организмами – бактериями. Они могут поражать различные органы и системы, вызывая воспаление и нарушение их функций. Существует множество видов бактерий, некоторые из которых безвредны, а другие – патогенны, то есть способны вызывать заболевания. Пути заражения бактериями разнообразны: воздушно-капельный, контактный, пищевой, через поврежденную кожу или слизистые оболочки.
Отличия вирусной и бактериальной инфекции
Определить, вирусная или бактериальная инфекция поразила ребенка, бывает непросто, так как симптомы часто схожи. Однако существуют ключевые различия, которые помогут в диагностике.
| Признак | Вирусная инфекция | Бактериальная инфекция |
|---|---|---|
| Начало | Постепенное | Внезапное, острое |
| Температура | Невысокая, умеренная | Высокая, часто выше 38,5°C |
| Общее состояние | Слабость, утомляемость | Сильная слабость, интоксикация |
| Кашель | Сухой, надсадный | Влажный, с гнойной мокротой |
| Насморк | Прозрачный, водянистый | Густой, желто-зеленый |
| Анализ крови | Нормальное или незначительное повышение лейкоцитов | Значительное повышение лейкоцитов, увеличение СОЭ |
| Лечение | Симптоматическое, противовирусные препараты | Антибиотики |
Симптомы бактериальных инфекций у детей
Симптомы бактериальных инфекций у детей могут варьироваться в зависимости от локализации инфекции и возраста ребенка. Важно обращать внимание на любые изменения в состоянии здоровья малыша.
- Инфекции верхних дыхательных путей: высокая температура, насморк с густыми выделениями, боль в горле, кашель, увеличение лимфатических узлов.
- Инфекции нижних дыхательных путей (пневмония, бронхит): высокая температура, кашель с гнойной мокротой, одышка, боль в груди.
- Инфекции мочевыводящих путей: боль при мочеиспускании, частое мочеиспускание, недержание мочи, боль в пояснице.
- Кишечные инфекции: рвота, диарея, боль в животе, повышение температуры.
- Инфекции кожи и мягких тканей: покраснение, отек, боль, гнойные выделения.
- Скрытая бактеремия: длительная лихорадка без видимого источника инфекции.
- Ботулизм: слабость, затрудненное глотание, нарушение зрения.
- Брюшной тиф: высокая температура, слабость, головная боль, сыпь.
Диагностика бактериальных инфекций
Для точной диагностики бактериальной инфекции необходимо обратиться к врачу и сдать анализы.
- Анализ крови: общий анализ крови позволяет оценить количество лейкоцитов, СОЭ и другие показатели, которые могут указывать на наличие инфекции.
- Анализ мочи: общий анализ мочи позволяет выявить наличие бактерий и воспалительных изменений в мочевыводящих путях.
- Бактериологический посев: посев позволяет идентифицировать конкретный вид бактерии и определить ее чувствительность к антибиотикам. Это очень важный анализ, который помогает подобрать наиболее эффективное лечение.
- ПЦР-диагностика: позволяет выявить ДНК бактерии в биологическом материале.
Лечение бактериальных инфекций
Основным методом лечения бактериальных инфекций является антибиотикотерапия. Однако антибиотики должен назначать только врач, учитывая возраст ребенка, тяжесть инфекции и чувствительность бактерии к препарату. Помимо антибиотиков, может быть назначено симптоматическое лечение: жаропонижающие, обезболивающие, обильное питье.
В тяжелых случаях может потребоваться госпитализация. Я помню, как однажды у моего сына поднялась высокая температура и появились признаки пневмонии. Врач сразу же госпитализировал его, и благодаря своевременному лечению мы смогли избежать серьезных осложнений.
Осложнения бактериальных инфекций
При отсутствии своевременного и адекватного лечения бактериальные инфекции могут привести к серьезным осложнениям.
- Сепсис: генерализованная инфекция, характеризующаяся поражением различных органов и систем.
- Инфекционно-токсический шок: тяжелое состояние, вызванное массивным высвобождением токсинов в кровь.
- Почечная недостаточность: нарушение функции почек.
- Сердечно-сосудистая недостаточность: нарушение функции сердца.

Профилактика бактериальных инфекций
Профилактика бактериальных инфекций включает в себя соблюдение правил гигиены, вакцинацию и укрепление иммунитета.
- Регулярное мытье рук: особенно после посещения общественных мест и перед едой.
- Вакцинация: вакцинация помогает защитить ребенка от многих опасных бактериальных инфекций.
- Здоровый образ жизни: правильное питание, достаточный сон, физическая активность.
- Избегание контакта с больными людьми: особенно во время эпидемий.
Типичные ошибки при лечении
Самолечение бактериальных инфекций у детей может быть опасным. Неправильный выбор антибиотиков или несоблюдение дозировки может привести к развитию устойчивости бактерий к препаратам и ухудшению состояния ребенка.
Я часто вижу, как родители, испугавшись температуры у ребенка, начинают давать ему антибиотики, которые остались от предыдущего лечения. Это очень опасно! Антибиотики должен назначать только врач после проведения необходимых анализов.
FAQ
Вопрос: Что делать, если у ребенка высокая температура и насморк?
Ответ: Обратитесь к врачу для диагностики и назначения лечения.
Вопрос: Какие анализы необходимо сдать для диагностики бактериальной инфекции?
Ответ: Анализ крови, анализ мочи, бактериологический посев.
Вопрос: Можно ли лечить бактериальную инфекцию в домашних условиях?
Ответ: Только по назначению врача и под его контролем.
Вопрос: Как укрепить иммунитет ребенка?
Ответ: Правильное питание, достаточный сон, физическая активность, вакцинация.
